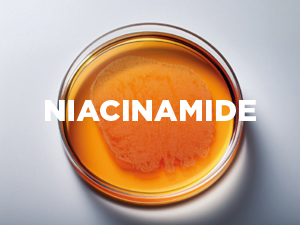

✨ Unlock youthful radiance with every mask – because your skin deserves the best! 🌿
Skin Republic Retinol Infusion Sheet Mask is a dermatologist-tested, biodegradable Korean skincare innovation proven to reduce wrinkles and pigmentation visibly after one use. With 95% of users seeing continued improvement after 4 weeks, this mask accelerates skin renewal and collagen production, targeting fine lines, uneven texture, and age spots for a smoother, more youthful complexion.

Trustpilot
2 months ago
2 weeks ago